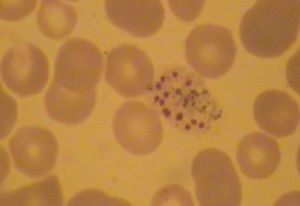
間日瘧原蟲 間日瘧原蟲

簡介
間日瘧原蟲(Plasmodiumvivax)是引起人類瘧疾的病原蟲之一。其中間宿主為按蚊、終末宿主為人,通過中間宿主傳播疾病,使被感染的人患瘧疾。由於其每個裂殖子進入紅細胞內形成新的裂殖子的周期為48小時,故稱之為間日瘧原蟲。
間日瘧原蟲引起的瘧疾傳染三要素為易感動物、傳染媒介和傳染源。感染後通常表現為周期性寒戰、發熱和出汗退熱等,隨著發作次數增多,患者可能出現貧血、脾腫大及兇險型瘧疾等。
中間寄主:二個(人、雌按蚊)
有世代交替現象:無性世代:在人體內進行;有性世代:在雌按蚊體內進行
傳播媒介:雌按蚊
生活史
寄生於人的間日瘧原蟲的生活史分3個時期:
間日瘧原蟲傳播媒介①裂體生殖,在人體中進行。帶蟲的媒介雌按蚊(在中國主要為中華按蚊、大劣按蚊、微小按蚊)的唾液中有許多細小長形的子孢子。蚊吸人血時,子孢子隨唾液注入人體血中,在半小時內即進入肝臟的實質細胞並在那裡行裂體生殖,這一階段稱紅細胞外期。紅細胞外期短的為7天,可產生1萬以上的裂殖子。有的子孢子進入肝細胞不馬上發育,而呈休眠狀態,稱休眠子。數月、1年、甚至更長的時間之後,才開始裂體生殖形成裂殖子。所有在肝細胞中形成的裂殖子,都不重新感染新的肝細胞,而是直接進入血液侵入紅細胞中,開始紅細胞內的裂體生殖,這一階段稱紅細胞內期。裂殖子先形成早期的滋養體,此時細胞質包圍了一大空泡,並與核形成戒指狀,特稱為環狀體期。早期滋養體用胞口吞食紅細胞的細胞質,不斷長大,統稱滋養體。此時經消化吸收後殘留下的血紅蛋白的血紅素,在蟲體內成為許多黃褐色的顆粒狀物,稱為瘧色粒。與此同時,紅細胞膜出現點狀損傷,用吉氏液染色時呈現淡紅色小點,稱薛氏點。滋養體長大之後,核開始連續分裂,即所謂裂殖體。裂殖體成熟時(核數目12~24個,通常16個),核分裂停止,細胞質圍繞著核開始分割成與核數目相等的裂殖子,裂殖子的集團在未破紅細胞而出之前合稱為分裂體。紅細胞破裂,分裂體中的裂殖子散出,各侵入一個新的紅細胞,再重複其紅細胞內的裂體生殖。每個無性生殖(即裂體生殖周期)就是裂殖子侵入紅細胞至下一代裂殖子破紅細胞而出的一個周期,共需48小時。每當紅細胞破裂,裂殖子散出時,其瘧色粒和其他代謝產物進入血液,使患者最初出現寒戰繼而發高熱。
②配子生殖,從人體開始,在蚊胃完成。在人體紅細胞中進行反覆裂體生殖後,一部分進入紅細胞的滋養體不再進行裂體生殖(即核不再分裂),而是長成雌配子母細胞或雄配子母細胞。當媒介按蚊吸病人的血時,雌雄配子母細胞便進入蚊胃,雄配子母細胞核分裂成4~8個,隨即有4~8條細胞質的絲狀突出,每一條含一個核,稱出絲,最後形成相同數目的絲狀小配子,雄性。每一雌配子母細胞在蚊胃中進一步成熟為一個大配子,雌性。雄配子在胃中與雌配子結合成合子,完成了配子生殖的過程。
③孢子生殖,在蚊體中進行。受精後的合子延長成錐狀,能動,故稱動合子。動合子穿過胃壁在血腔一側的蚊胃彈性纖維膜下形成了圓形的卵囊,卵囊逐漸增大,突出在胃腔中,其中的核進行反覆分裂,最後移入突出的細胞質中形成眾多的長形或新月形的子孢子。子孢子鑽破卵囊而出,進入蚊的血體腔中,隨蚊的血淋巴到達蚊的唾液腺內。在外界溫度為25□C時,約需8~12天完成。
裂體生殖
紅細胞外期
間日瘧原蟲生活史紅細胞內期
大量裂殖子侵入紅細胞,它們首先發育為中央有一空泡、核偏在一側的環狀滋養體,進一步發育為可伸出偽足的大滋養體,其體內不斷沉積出無法利用的血紅蛋白分解產物的顆粒沉積在紅細胞中,稱為瘧色素。成熟的大滋養體幾乎占滿了紅細胞,原蟲再進行裂體生殖,形成多個裂殖子,裂殖子成熟後,紅細胞膜破裂,每個裂殖子則侵入其他紅細胞。
由於大量紅細胞破裂以及裂殖子的代謝產物釋放到血液中,引起人生理上的一系列反應,臨床表現為高熱、寒戰交替出現的症狀,俗稱“打擺子”。
紅細胞前期原蟲第一次在紅細胞內進行裂體增殖的時期。
配子生殖
間日瘧原蟲間日瘧原蟲經過幾次裂體生殖後,一部分裂殖子侵入紅細胞後不再進行裂體生殖,而是分別發育為大、小配子母細胞。大配子母細胞比正常的紅細胞大1倍,小配子母細胞較小,核較疏鬆位於蟲體中央,瘧色素顆粒較小。可以在人體血液中存活30—60天。
如果遇到其他按蚊叮咬人時,配子母細胞可隨人血液進入按蚊胃中分別發育成熟。大配子母細胞發育為大配子,其形態變化不大;小配子母細胞則分裂3次,形成8個具鞭毛的小配子,大、小配子結合形成動合子。
孢子生殖
間日瘧原蟲的動合子穿過蚊胃壁形成卵囊,經不斷分裂形成大量的梭形子孢子,卵囊隨子孢子的成熟而破裂,子孢子經蚊的血淋巴聚集於唾液腺內,當按蚊再次叮人時,將子孢子注入新的寄主體內。
傳染要素及原理
傳染要素
間日瘧原蟲引起的瘧疾傳染髮生三要素為易感動物、傳染媒介、傳染源 。傳染原理
間日瘧原蟲瘧疾的發作,是達到一定數量的紅細胞內無性期(裂體增殖期)瘧原蟲對機體的刺激引起的,如間日瘧原蟲為血液10—500個/mL,惡性瘧原蟲為500—1300個。瘧疾發作周期和紅內期裂體增殖周期一致,間日瘧為隔日發作一次。
感染表現
間日瘧原蟲引起的典型的瘧疾發作表現為周期性的寒戰、發熱和出汗退熱三個連續階段。隨著瘧疾發作幾次後,患者繼之出現貧血、脾腫大及兇險型瘧疾等。貧血症狀以惡性瘧尤為嚴重。
在惡性瘧爆發流行時,有時也見於嚴重的間日瘧患者,發生兇險型瘧疾症狀,如腦型瘧疾、腎功能衰竭、重瘧貧血、嚴重水瀉等;其中常見的是腦型瘧疾,患者高燒、昏迷,不及時治療可致死亡。
防治
間日瘧原蟲引起的瘧疾防治原則,應根據瘧原蟲生活史和流行區實際情況,採用因地因時制宜的綜合防治措施。一方面用抗瘧藥殺滅人體內發育各階段的間日瘧原蟲,防止瘧疾發作及控制傳染源:另一方面積極開展防制媒介蚊蟲,以控制瘧疾的傳播。
相關研究
非洲人不再免疫
感染瘧疾後人體紅細胞的變化此前普遍認為,紅血球表面缺少名為Duffy蛋白質的人群對間日瘧原蟲具有天然的免疫力,因為Duffy是間日瘧原蟲的受體,沒有它瘧原蟲就無法進入血液。大多數非洲人的血液都呈Duffy陰性,即不具備此類蛋白質。
馬達加斯加一些呈Duffy陰性的居民也感染了間日瘧原蟲,這說明後者已成功繞過Duffy蛋白質,通過另一條道路進入了紅血球,Duffy已不再是間日瘧原蟲傳播的必要條件。
幫助亞太地區人類進化
2012年9月,《每日科學》的研究表明,人類的瘧疾通常由四種病原引起,其中間日瘧原蟲引起的瘧疾在亞太地區十分盛行,正是這種病原可促進人體基因進化,產生一種足以抵禦瘧疾病原的蛋白質,免遭瘧疾帶來的痛苦。
瘧疾寄生蟲一直處於不斷進化之中,它們同時也是促進人類基因組不斷進化的主要力量,通過引起基因突變的方式,它們還為人類提供一些防禦機制以幫助其生存,以防受到因自然選擇而遺留的疾病所產生的負面影響。